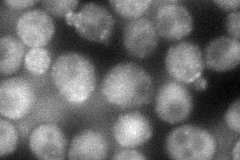
YHR161C
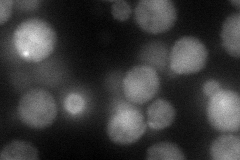
YHR161C
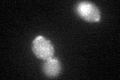
YHR161C
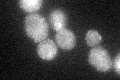
YHR161C
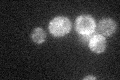
YHR161C

View description
Protein involved in clathrin cage assembly; binds Pan1p and clathrin; homologous to Yap1802p, member of the AP180 protein family
Localization:
Intensity:
Fold change:
Significance:
-
C’ GFP library in SD

bud neckN/A -
N' NOP1pr-GFP in SD
punctate,bud neck77.4038 -
N' TEF2pr-mCherry in SD
punctate,bud neck79.5065 -
N' NATIVEpr-GFP in SD

bud neck31.8049 -
N' TEF2pr-VC and Cyto-VN in SD

cytosol38.2386 -
C’ GFP library in SD+DTT
bud neckN/AN/ANo -
C’ GFP library in SD+H2O2
bud neckN/AN/ANo -
C’ GFP library in Starvation Media
bud neck38.871.46Yes -
C’ GFP library on the background of Pup2-DaMP

bud neck -
C’ GFP library on the background of CCT mutant

bud neck26.57261.00232No
